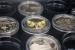
Kammer, 2024, ����� D32, ��� �������� ����� � �������� 32 ��

Kammer, 2024, Аркуш D32, для хранения монет в капсулах 32 мм
ТОП ПРОДАЖ!
88.00
Економ на доставці
2.20
з
"БК Доставкою"
.
Замовлення, оплачене до 16:00 по буднях, буде відправлено того ж дня.
Замовити: Аркуш D32, для хранения монет в капсулах 32 мм
Є на складі.
| Код товару: | 4409 |
| Матеріал: | полимер |
| Вага: | 85гр |
| Надійний захист та зручне зберігання ваших монет. Ці міцні листи допоможуть акуратно зберігати вашу колекцію. Підходять для альбомів King та Queen. Виготовлені з високозносостійкого полімерного матеріалу. Підвищена прозорість матеріалу забезпечує відмінну видимість, надійне зберігання та довговічність. Продумана конструкція. Кожне відділення закривається на замок, запобігаючи випаданню монет. Щільні прозорі відділення (розташування 5x6). Сумісні з альбомами інших виробників за розмірами. Ідеальне рішення для акуратного зберігання колекції. Технічні характеристики виробу: - діаметр осередку: 36,2 мм (для капсул діаметром 32 мм) - розмір зовнішнього листа: 235 x 285 мм - товщина матеріалу: 180-200 мкм (0,18-0,20 мм) - матеріал: полімер - колір: прозорий Виробник: Kamer Вага: 85 г |
|